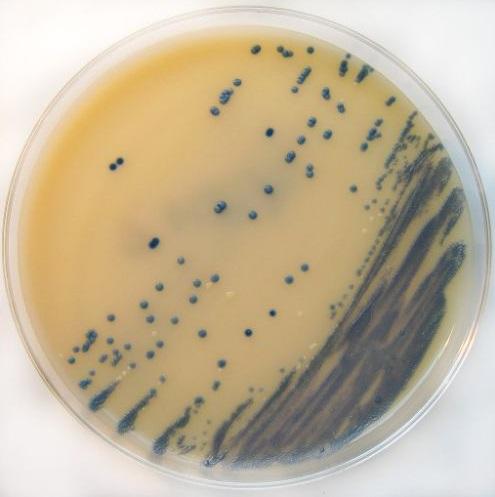

¿Qué es el agar M.R.S.?
El agar M.R.S. es un medio de cultivo sólido selectivo, utilizado para el aislamiento y recuento de bacterias ácido lácticas, especialmente del género Lactobacillus. Este agar fue creado en 1960 por Man, Rogosa y Sharpe, llevando el medio el mismo nombre, pero por su complejidad a menudo se utiliza la abreviación M.R.S.
Está compuesto por proteosa peptona, extracto de carne, extracto de levadura, glucosa, monoleato de sorbitán, fosfato dipotásico, acetato de sodio, citrato de amonio, sulfato de magnesio, sulfato de manganeso y agar.
Esta composición permite el buen desarrollo de las bacterias ácido lácticas provenientes de muestras clínicas, como heces, secreción vaginal, muestras orales y leche materna, así como de alimentos lácteos y cárnicos.
No se usa de manera rutinaria en los laboratorios clínicos, debido a que las bacterias ácido lácticas pocas veces están involucradas en procesos patológicos. Sin embargo, en el área de microbiología de alimento es más frecuente el uso del agar M.R.S.
Por otra parte, este medio es utilizado por algunos centros de investigación cuyo objetivo es el estudio de bacterias ácido lácticas.
Fundamento
El agar Man, Rogosa y Sharpe posee una composición bastante compleja. Al desglosar la función que cumple cada uno de sus componentes, se puede explicar su fundamento.
La proteosa peptona, el extracto de carne, el extracto de levadura y la glucosa son nutrientes que proporcionan la fuente de carbono, nitrógeno, vitaminas y minerales necesarios para el crecimiento bacteriano. Además, la glucosa es la fuente de energía universal empleada en la mayoría de los medios de cultivo.
Por otra parte, para favorecer el crecimiento de las bacterias ácido lácticas, es necesario la presencia de cofactores (cationes) indispensables en el metabolismo de los Lactobacillus y bacterias afines. Estos compuestos son las sales de sodio, magnesio y manganeso.
Asimismo, el monoleato de sorbitán o polisorbato 80 son una fuente de ácidos grasos importante al ser absorbidos como nutrientes.
Además, el monoleato de sorbitán y el citrato de amonio actúan inhibiendo el desarrollo de la flora acompañante, en especial bacterias gramnegativas, proporcionando el carácter selectivo de este agar.
Finalmente, el agar-agar es el que brinda la consistencia sólida al medio.
Existe otras variantes del agar Man Rogosa Sharpe: una de ellas es el suplementado con cisteína (M.R.S.c), muy útil para el aislamiento de bifidobacterias, entre otros microorganismos. Por otra parte, está el medio MRS suplementado con neomicina, paromomicina, ácido nalidíxico y cloruro de litio, especial para el recuento selectivo de bifidobacterias en productos lácteos.
Preparación
Pesar 68,25 gramos del medio deshidratado y disolver en un litro de agua destilada. Dejar reposar por 5 minutos. Para disolver en su totalidad, llevar a una fuente de calor agitando frecuentemente y dejar hervir de 1 a 2 minutos. Esterilizar en autoclave a 121 °C por 15 minutos.
Al salir del autoclave dejar reposar unos minutos y distribuir aún caliente en placas de Petri estériles.
Dejar solidificar e invertir las placas, ordenar en plaqueros y guardar en nevera hasta su uso. Dejar que las placas tomen temperatura ambiente antes de utilizarlas.
El pH del medio debe quedar en 6,4 ± 0,2. Algunas casas comerciales recomiendan pH entre 5,5 a 5,9.
El medio deshidratado es de color beige y preparado es ámbar oscuro.
Tanto el medio deshidratado como las placas preparadas deben almacenarse de 2 a 8 °C.
Usos
Las placas de agar M.R.S. pueden sembrarse en superficie (agotamiento o con espátula de Drigalski). También puede ser sembrada por profundidad. Las placas deben incubarse a 37 °C en microaerofilia (4% de O2 y 5-10% de CO₂) durante 24 a 72 horas.
El método de sembrado se elige de acuerdo a la finalidad que se persigue (aislamiento o recuento).
Características de las colonias
Las colonias presuntivas de Lactobacillus crecen de color blanquecino y presentan una apariencia mucoide o cremosa en este agar. Posteriormente deben identificarse.
Aislamiento de bacterias ácido lácticas
- Para aislar estas bacterias se utiliza el sembrado por superficie. Las muestras a sembrar requieren un procedimiento previo.
- En el caso de muestras de leche materna, se recomienda centrifugar 1 ml de la muestra a 14.000 rmp por 10 minutos, con la finalidad de remover la capa grasa. Se descartan 900 µl, y en los 100 µl restantes se suspende el sedimento y se vierte en la superficie del agar M.R.S. Seguidamente se debe distribuir uniformemente con una espátula de Drigalski.
- En el caso de muestras de heces, se pesa un (1) gramo de heces y se homogeneiza en 9 mL de agua peptonada estéril 0,1%, correspondiente a una dilución 1/10. Luego se realizan diluciones seriadas, hasta obtener una dilución final de 10-4. Se toman 100 μl de las diluciones 10-2, 10-3 y 10-4 y cada dilución se siembra en agar MRS, distribuyendo uniformemente con una espátula de Drigalski.
Recuento de bacterias ácido lácticas
- En este caso el sembrado se realiza por profundidad.
- Para muestras de leche materna se toma 1 mL y se coloca en un tubo de plástico cónico estéril. Se le adiciona agar MRS a una temperatura aproximada de 40 °C hasta un volumen final de 25 mL, obteniendo una mezcla homogénea. Posteriormente, se vierte en placas de Petri estériles de manera uniforme y se deja reposar hasta su polimerización.
- Para muestras de heces se hacen las diluciones como se describió anteriormente. Se toma 1 mL de cada dilución y se coloca en tubos de plástico cónicos estériles. Se adiciona agar MRS fundido hasta un volumen de 25 mL. La mezcla de cada dilución se vierte de manera uniforme en placas de Petri estériles. Finalmente, se deja reposar hasta su polimerización.
En investigación
Cada día cobra más interés el estudio de las bacterias ácido lácticas. Especialmente los investigadores buscan conocer nuevas cepas y sus potencialidades como fermentos iniciadores para la estandarización en la fabricación de productos lácteos, entre otros usos.
- Algunos investigadores utilizaron el agar M.R.S. para realizar un estudio en el que aislaron, identificaron y caracterizaron bacterias ácido lácticas presentes en un queso venezolano ahumado andino artesanal. En el queso encontraron la presencia de bacteria de los géneros Lactococcus y Lactobacillus, y concluyeron que las mezclas de cepas aisladas son adecuadas como cepas iniciadoras en la fabricación de quesos a partir de leche pasteurizada.
- Otros investigadores emplearon el agar M.R.S. para investigar la presencia de bacterias ácido lácticas en el tubo digestivo de lechones, con el fin de usarlas como probióticos nativos que aumenten la productividad de lechones sanos. Con este medio lograron aislar cuatro especies: Lactobacillus johnsonii, Lactobacillus brevis, Enterococcus hirae y Pediococcus pentosaceus.
- Otros estudiosos utilizaron el agar M.R.S. para evaluar bacterias ácido lácticas (BAL) y bifidobacterias con potencial probiótico en leche materna y heces de lactantes. Lograron aislar 11 BAL y 3 Bifidobacterias sp en la leche materna, y 8 BAL y 2 Bifidobacterias sp. en heces. Todas cumplieron ciertos parámetros que las acreditan como bacterias con actividad probiótica. Los autores concluyeron que tanto la leche materna como las heces de los lactantes amamantados de forma exclusiva sirven como fuentes naturales de bacterias probióticas.
Control de calidad
Para evaluar la calidad del agar M.R.S. se pueden usar cepas controles tales como:
Lactobacillus fermentum ATCC 9338, Lactobacillus casei ATCC 393, Bifidobacterium bifidum ATCC 11863, Lactobacillus plantarum MKTA 8014, Lactobacillus lactis MKTA 19435, Pediococcus damnosus MKTA 29358, Escherichia coli y Bacillus cereus.
Los resultados esperados son crecimiento satisfactorio para las 6 primeras bacterias, mientras que E. coli y Bacillus cereus deben ser inhibidas en su totalidad.
Referencias
- M.R.S. agar. Recuperado de britanialab.com.